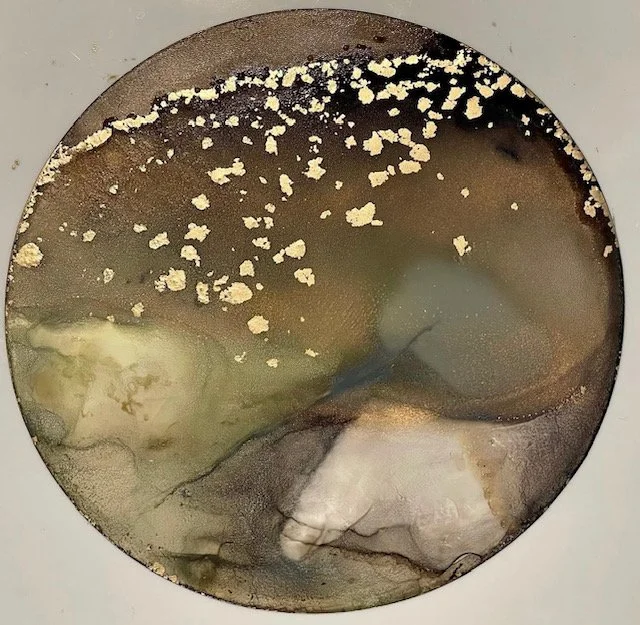

Forest of Feathers






Beneath the Brim








